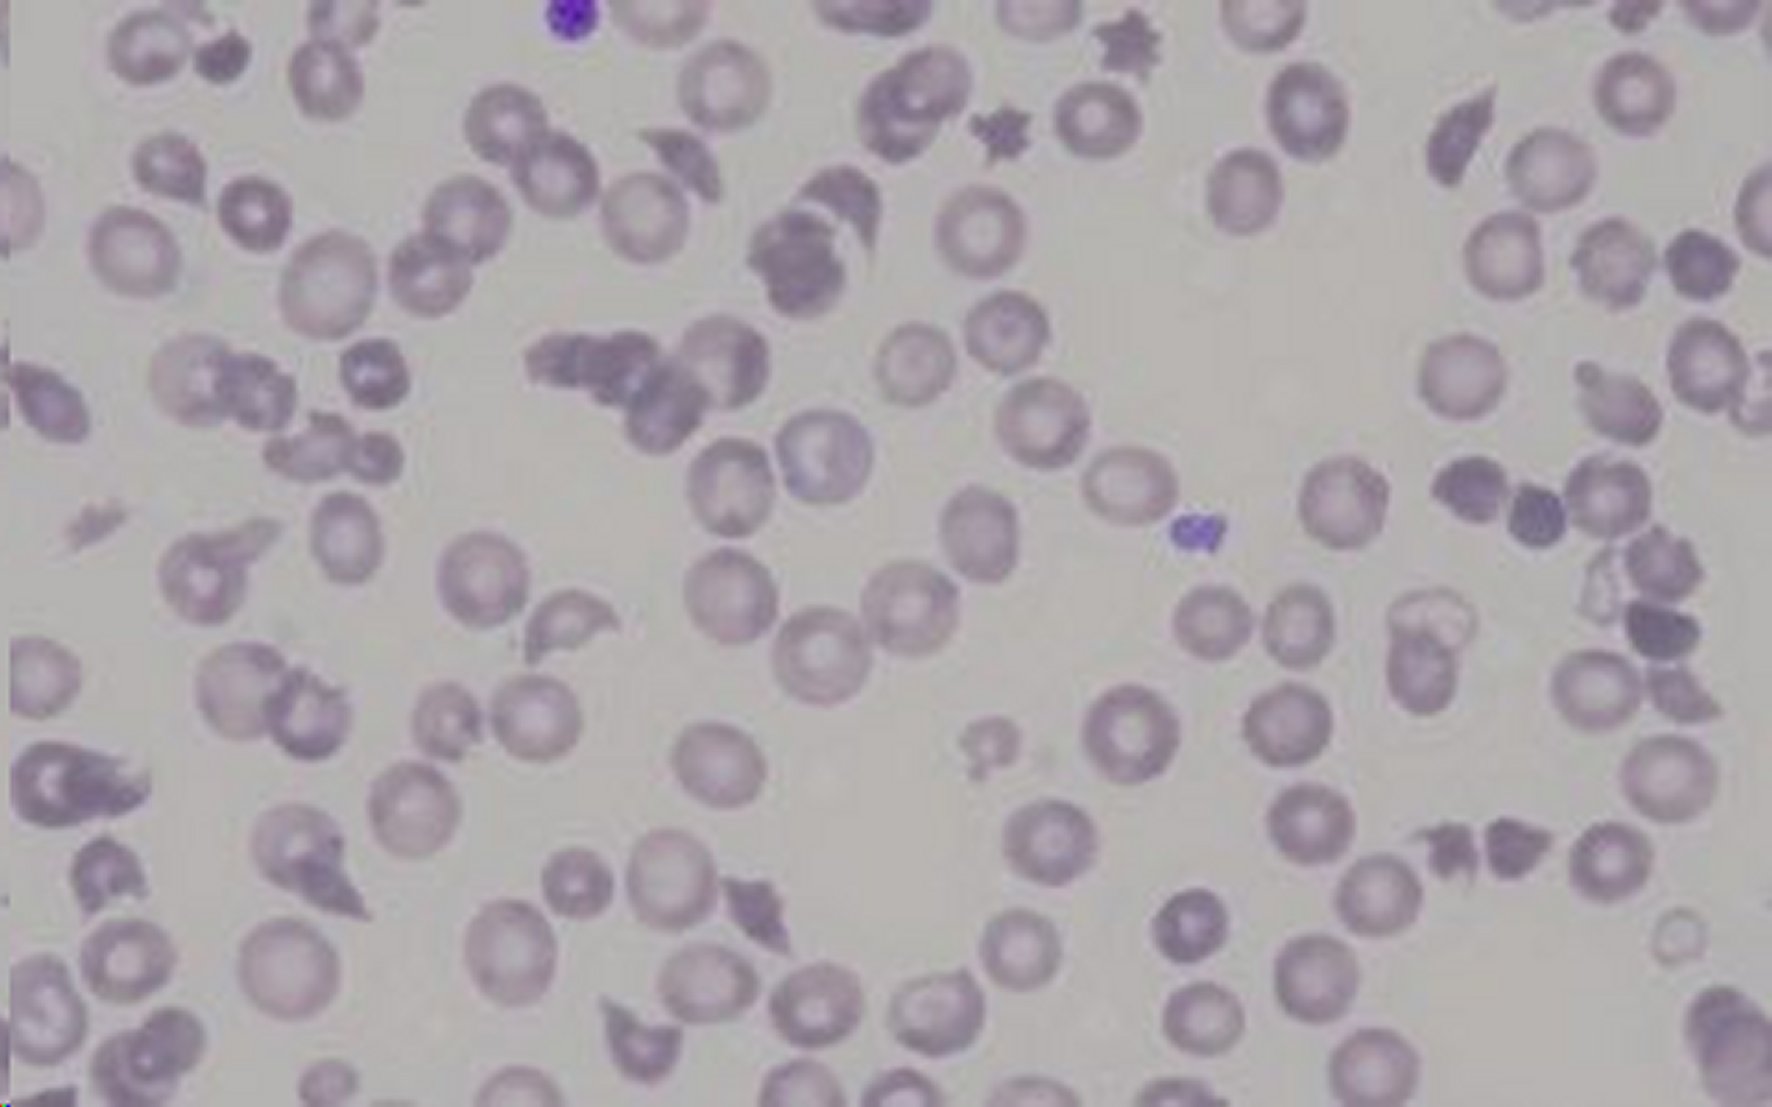

Case Report
Thrombotic microangiopathy secondary to Capnocytophaga canimorsus bacteremia
Microangiopatía trombótica secundaria a bacteriemia por Capnocytophaga canimorsus
Thrombotic microangiopathy secondary to Capnocytophaga canimorsus bacteremia
Iberoamerican Journal of Medicine, vol. 6, núm. 1, pp. 28-32, 2024
Hospital San Pedro

Recepción: 18 Agosto 2023
Corregido: 07 Noviembre 2023
Aprobación: 15 Noviembre 2023
Abstract: Capnocytophaga canimorsus is an Anaerobic Gram-Negative bacterium present in the oral microbiology of cats and dogs. It can produce infections in humans, being capable of causing severe complications with the development of septic shock. There are known cases where this bacterium developed medical complications like thrombotic microangiopathy and disseminated intravascular coagulation. We have the case of 79 years old male that developed thrombotic microangiopathy and splenic infarction linked to bacteraemia by Capnocytophaga canimorsus. Due to its severity, it was necessary to start renal replacement therapy and several sessions of plasmapheresis with good evolution.
Keywords: Thrombotic microangiopathy, Septic shock, Bacteremia, Kidney injury.
Resumen: Capnocytophaga canimorsus es una bacteria anaerobia gramnegativa presente en la microbiología oral de gatos y perros. Puede producir infecciones en humanos, siendo capaz de provocar un diagnóstico severo con desarrollo de shock séptico. Existen casos descritos con complicaciones médicas como Microangiopatía Trombótica y Coagulación Intravascular Diseminada. Presentamos el caso de un varón de 79 años que desarrolló microangiopatía trombótica e infarto esplénico asociado a bacteriemia por Capnocytophaga canimorsus. Por su gravedad, fue necesario iniciar terapia de reemplazo renal y varias sesiones de plasmaféresis con buena evolución.
Palabras clave: Micrpangiopatía trombótica, Shock séptico, Bacteriemia, Daño renal.
INTRODUCTION
Capnocytophaga canimorsus is an Anaerobic Gram-Negative bacterium with a slow growth present in the oral microbiology of cats and dogs [1]. It can produce infections in humans that have suffered a bite or scratch of these animals, being capable of causing severe complications with the development of sepsis and septic shock [2, 3]. There are known cases where this bacterium developed medical complications like thrombotic microangiopathy and disseminated intravascular coagulation [4, 5]. We have the case of a 79 years old male that developed thrombotic microangiopathy and Splenic infarction linked to bacteraemia by Capnocytophaga canimorsus.
CASE REPORT
A 79 years old male, with a medical history of longstanding high blood pressure treated with Valsartan 160 mg every 12 hours and an acute myocardial infarction revascularized with 3 stents one year and a half before the actual admission.
He went to the emergency department due to a syncope, having also quivering, malaise, fever, abdominal pain, nausea and diarrhoea. He returned adequate results in the physical examination, TA 180/90 mmHg: 90 beats per minute, 18 breaths per minute, 96% of oxygen saturation, breathing room air with no findings in the physical examination.
In the analysis, it was remarkable the sharp deterioration of the kidney function and the elevation of acute phase reactants (Table 1). An echocardiogram was done and a thoracic AngioCT with no pathologic findings. Blood cultures were extracted, and an antibiotic treatment with Piperacillin-Tazobactam began whilst he was hospitalized. He presented a bad prognosis in the first hours, with arterial hypertension, low grade fever and deterioration of kidney function (Table 1) developing anuria and severe platelet count. It was discussed with intensive medicine care and his admission in the Intensive Medicine Unit was determined. An abdominal CT was made with no contrast with the pathologic findings. The antimicrobial therapy was raised to Meropenem.

Start of replacement therapy was performed at the beginning of +48 h. Plasma exchange was performed at the beginning of 4th day, during the period of +4th day and twice a time during the period of +6th day (at the beginning as well as the end).
BE: Base excess; AST: Aspartate aminotransferase; ALT: Alanine aminotransferase; CRP: C-reactive protein; PCT: Procalcitonin; WBC: White blood cells; PT: Prothrombin; aPTT: Activated partial thromboplastin; Hemol.: Hemolyzed; Not calc: Not calculable.
The Microbiology service reported the growth of Capnocytophaga canimorsus in the blood cultures. These cultures were positive in the first 24 hours. The bacteria were identified by mass espectometry (MALDI-TOF). The patient being interrogated again and referred that he was in contact with dogs and he sustained scratches and a light bite wound 4 or 5 days ago. During the first days, the evolution from a clinic point of view was bad, with arterial hypertension, requiring continuous perfusion of clevidipine. Additionally, the patient kept anuria and needed nasal oxygen therapy of high flow, due to his respiratory distress. From the analytic point of view, the kidney function, continued with severe platelet count, despise the transfusion of 3 platelet pooles, increase in bilirubin and LHD (see analytic evolution in Table 1). In light of the deterioration, a continuous renal replacement therapy began and a contrast Thoracoabdominal tomography was made. Ground glass infiltrations were observed in both pulmonary parenchyma and the lack of contrast of a significant proportion of the splenic parenchymal, radiologically compatible with infarct (Figure 1).

72 hours after the admission the patient had signals of anaemia with bleeding, assessed by the haematology service, the blood smear presented schistocytes (Figure 2) so the development of thrombotic microangiopathy (TMA) due to Capnocytophaga canimorsus was suspected. The Haematology, Nephrology and Intensive Medice the start of Plasmapheresis sessions (see Table 1, arrows) assessed it in conjunction. A study displayed the activity of ADAMTS13 of 36% (>5-10 %) with negative antiADAMTS13 antibodies. Supporting the diagnosis of MAT 2ª, also a direct study of Coombs was made, being the result negative.
After the renal replacement therapy and the plasmapheresis sessions, the continuation of antibiotic therapy showed a good evolution, with gradual improvement of the renal function and beginning of diuresis, rapid rise of platelet amount with no signs of anaemia, with lowering levels of bilirubin and LDH. Additionally, an improvement respiratory situation, being able to discontinue the oxygen therapy.
The patient was discharge from the Intensive Medical Unit the eleventh day since admission. The patient showed a good evolution in the hospital ward following the antimicrobial therapy with Meropenem for 14 days (due to its good evolution), being discharge with a normal renal function 21 days after his admission in the hospital.
DISCUSSION
Capnocytophaga canimorsus is a negative anaerobic Gram bacterium of slow growth, which can be part of the oropharyngeal microbiota in cats and dogs. It can cause serious infection on the human being with a mortality rate of 25% [1, 6].
It can produce meningitis, endocarditis, peritonitis, pneumonia, osteomyelitis and abscesses although the most common type of infection is the skin and soft tissue infection due to animal bite or scratch [6]. This infection can be caused in immunocompetent patients, although asplenia, alcoholism and immunosuppression are risk factors of developing Capnocytophaga canimorsus infection [3, 6, 7]. The incubation period up to the onset of symptoms since the contact with the animal can vary from 1 to 7 days [3] and it must be taken into account that it has a slow growth [6], so in case of suspicion of infection due to a dog bite, the possibility of Capnocytophaga canimorsus culpability must be contemplated.
Among the complication that this microorganism produces, it can be found the development of thrombotic microangiopathy (TMA) being this one uncommon [5]. Tani and collaborators published a literature review where they reported 10 cases of C. carnimorsus infection with TMA complications [5].
The term thrombotic microangiopathy (TMA) contains a heterogenous group of rapidly evolving and potentially deadly diseases characterized by the presence of Thrombocytopenia and Microangiopathic haemolytic anemia [8].
Among the TMA we find the secondary TMA, associated with an identify etiological agent (drugs, infections, malignancies) [9] when the treatment fundamentally consists in treating the underlying cause [8, 9].
In the presence of Thrombocytopenia and microagniopathic haemolysis (platelets <150000/mm3, high LHD, negative direct Coombs, schistocytes in blood smears) the presence of TMA was suspected [8, 9]. In light of this, diagnosis and the patient’s bad progress it was decided to add the treatment for bacteriemia C. canimorsus, the carrying out of an urgent plasma exchange (PE). Four sessions in consecutive days were made until the improvement from a clinic and analytic point of view.
The use of plasmapheresis for a C. canimorsus’s TMA development has been described in literature [5, 10, 11] with a global survival rate (in patients that a PE was made) of 22% [5].
Likewise, cases have been described where a splenic ischemia developed (found by imaging tests) in patients showing TMA due to the bacteriemia Capnocytophaga canimorsus [4].
CONCLUSIONS
Given the potential severity of this entity, it must be taken into account the possible development of TMA infections by C. canimorsus (or the record of a dog bite, provided the slow growth of this bacteria) to make a clinical suspicion and early diagnosis. This will allow us to lay down appropriate therapeutic measures (being the most important the treatment of the infection) in these cases, assessing the possibility of doing a plasma exchange in light of severe symptoms and bad evolution of the patient.
CONFLICT OF INTERESTS
The authors have no conflict of interest to declare. The authors declared that this study has received no financial support.
REFERENCES
1. Gaastra W, Lipman LJ. Capnocytophaga canimorsus. Vet Microbiol. 2010;140(3-4):339-46. doi: 10.1016/j.vetmic.2009.01.040.
2. Nakayama R, Miyamoto S, Tawara T, Aoyagi A, Oguro T, Kobayashi N, et al. Capnocytophaga canimorsus infection led to progressively fatal septic shock in an immunocompetent patient. Acute Med Surg. 2022;9(1):e738. doi: 10.1002/ams2.738.
3. Hundertmark M, Williams T, Vogel A, Moritz M, Bramlage P, Pagonas N, et al. Capnocytophaga canimorsus as Cause of Fatal Sepsis. Case Rep Infect Dis. 2019;2019:3537507. doi: 10.1155/2019/3537507.
4. Brichacek M, Blake P, Kao R. Capnocytophaga canimorsus infection presenting with complete splenic infarction and thrombotic thrombocytopenic purpura: a case report. BMC Res Notes. 2012;5:695. doi: 10.1186/1756-0500-5-695.
5. Tani N, Nakamura K, Sumida K, Suzuki M, Imaoka K, Shimono N. An Immunocompetent Case of Capnocytophaga canimorsus Infection Complicated by Secondary Thrombotic Microangiopathy and Disseminated Intravascular Coagulation. Intern Med. 2019;58(23):3479-82. doi: 10.2169/internalmedicine.3110-19.
6. Leiva J, del Pozo JL. [Fastidious gram-negative rods: HACEK group, Capnocytophaga and Pasteurella]. Enferm Infecc Microbiol Clin. 2017;35(Supl 3):29-43.
7. Butler T. Capnocytophaga canimorsus: an emerging cause of sepsis, meningitis, and post-splenectomy infection after dog bites. Eur J Clin Microbiol Infect Dis. 2015;34(7):1271-80. doi: 10.1007/s10096-015-2360-7.
8. Romero S, Sempere A, Gómez-Seguí I, Román E, Moret A, Jannone R, et al. Practice guidelines for the emergency treatment of thrombotic microangiopathy. Med Clin (Barc). 2018;151(3):123.e1-123.e9. doi: 10.1016/j.medcli.2018.01.013.
9. Scully M, Hunt BJ, Benjamin S, Liesner R, Rose P, Peyvandi F, et al. Guidelines on the diagnosis and management of thrombotic thrombocytopenic purpura and other thrombotic microangiopathies. Br J Haematol. 2012;158(3):323-35. doi: 10.1111/j.1365-2141.2012.09167.x.
10. Smeets NJL, Fijnheer R, Sebastian S, De Mast Q. Secondary thrombotic microangiopathy with severely reduced ADAMTS13 activity in a patient with Capnocytophaga canimorsus sepsis: a case report. Transfusion. 2018;58(10):2426-9. doi: 10.1111/trf.14829.
11. Maezawa S, Kudo D, Asanuma K, Takekoshi D, Egashira R, Kushimoto S. Severe sepsis caused by Capnocytophaga canimorsus complicated by thrombotic microangiopathy in an immunocompetent patient. Acute Med Surg. 2016 23;4(1):97-100. doi: 10.1002/ams2.222.
Notas de autor
echicote@riojasalud.es